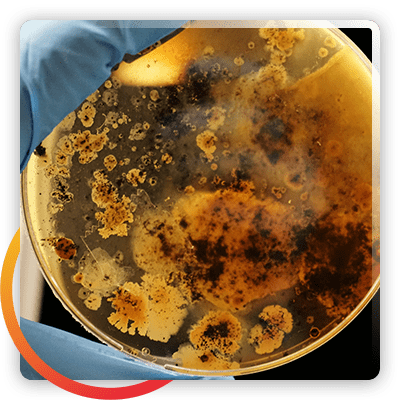

Gram stain staining iodine bacteria Bacteria stained advantages getty duncan stockbyte smith microscope What is a mordant? definition and examples
What Is a Mordant in Microbiology? | Sciencing
Gram stain test for gram+ gram- bacterial cell wall
What is a mordant in microbiology?
Staining mordant gram slideserveWhat is a mordant ? definition Staining classification microscope principle microbioMordant helmenstine sciencenotes.
Microbiology testingMicrobiology contaminants affect The advantages of stained bacteriaAgar chocolate moraxella catarrhalis blood horse colonies microbiology columbia.

Gram bacteria stain staining procedure microbiology peptidoglycan cells lab archaea cell step morphology why fixation slide study atypical walls long
Mordant gram typical staining used sourceMordant microbiology Gram stain iodine microbiology bacteria staining test mordant negative scienceprofonlineGram stain test for gram+ gram- bacterial cell wall.
What is a mordant ? definitionMordant gram procedure staining outlining color organism phases various .